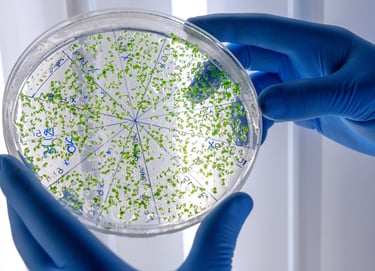

AVAIL SPECIAL DISCOUNTS ON PACKAGE DEALS AND MULTIPLE ORDERS - EXCLUSIVELY FOR STUDENTS AND RESEARCHERS WORKING IN PUBLIC UNIVERSITIES AND COLLEGES

Our Services




Academic/Scientific Services
Tailored academic services including peer review, plagiarism analysis, and journal suitability assessments
Editing Services
Comprehensive editing for articles, theses, and conference materials to enhance clarity and quality

Our Expertise

Medicine/Pharmaceutical Sciences
Physical Sciences
Life Sciences










Chemistry/Chemical Engineering
Material Science & Engineering
Environmental Science & Engineering






Computer Science
Electronics & Technology
Humanities & Social Sciences
QUETZAL EDITS
© 2025. All rights reserved.
